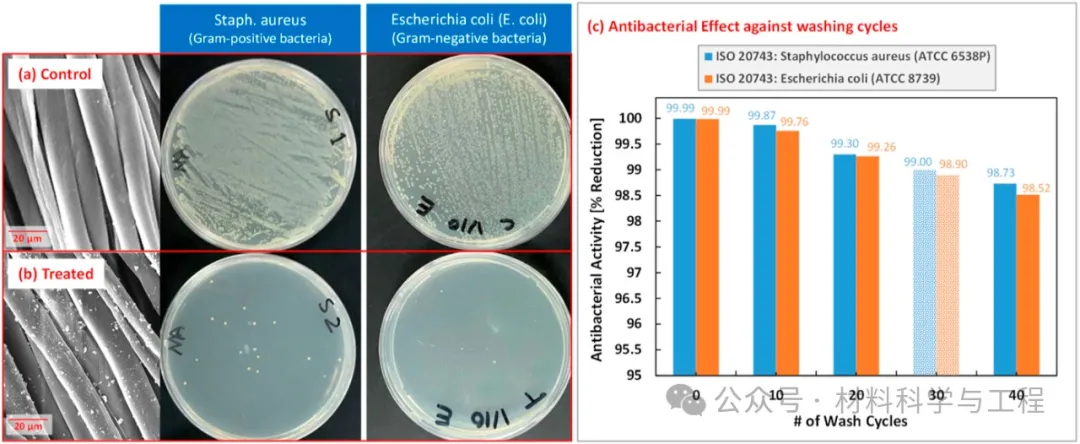

一种新型涂层工艺,实现衣物高效抗菌且耐用!
2024-06-20 13:26:40
作者:材料科学与工程 来源:材料科学与工程
分享至:
住酒店或医院的时候
很多人担心床上用品、纺织品
有没有消毒干净!?
好消息来了!
科研人员开发了一种涂层工艺
可以实现抗菌又耐用!
对棉织物进行改性以获得显著的新特性,对于创造多功能纺织品具有重要意义,可以应对不同行业的挑战。医院获得性感染是纺织品面临的关键挑战之一,可通过使用抗菌织物来预防。研究表明,二氧化钛(TiO2)纳米颗粒(NP)对流行微生物(如大肠杆菌和金黄色葡萄球菌)具有光催化抗菌应用。日前,来自沙特得科研人员利用了一种新开发的涂层工艺,包括对棉布进行化学改性和纳米涂层,以实现可安全使用、耐用、高效抗菌的纺织品,有望用于医疗保健、酒店业等领域。相关成果以题为“Enhanced antimicrobial performance of textiles coated with TiO2 nanoparticles”发表在Journal of Industrial Textiles。https://journals.sagepub.com/doi/10.1177/15280837241233743图1 TiO2纳米粒子涂层抗菌棉纺织品的制备步骤。对所用材料的性能进行了全面的表征,并研究了纯棉织物上NPs涂层的质量。使用标准微生物技术进行细菌培养和菌落计数。细菌研究表明,与对照棉织物相比,TiO2纳米粒子涂层织物表现出显著的抗菌性能,对金黄色葡萄球菌和大肠杆菌的细菌生长减少了99.99%。图2 未涂覆(a)和涂覆(b)的棉布在不同放大倍数下的SEM图像。涂层织物清楚地显示了TiO2纳米粒子簇的覆盖和分布。还通过使用标准方案洗涤涂层织物并重复定性和抗菌表征来进行涂层耐久性分析。耐久性研究表明,涂层技术具有卓越的性能,可承受至少40倍的密集洗涤循环,对金黄色葡萄球菌和大肠杆菌的细菌生长减少>98%。这些结果证明了所提出的工艺的有效性和商业适用性,可以生产具有卓越抗菌性能的棉纺织品,从而减少医院感染。图3 对照与暴露于金黄色葡萄球菌和大肠杆菌的处理织物“24小时孵育”。通过培养试验的结果验证了抗菌性能。
本文研究的涂层工艺在医疗保健、酒店业等领域具有商业应用潜力。经过处理的棉织物具有卓越耐用的抗菌性能,加上处理过程的可扩展性和成本效益,可在约100亿美元的全球抗菌保健织物市场和约180亿美元的世界抗菌酒店亚麻布市场中占据重要市场份额,2020年至2025年的复合年增长率(CAGR)>7%。
Journal of Industrial Textiles
该刊由英国知名学术出版商Sage所出版,主要发表技术纺织品、非织造布、涂层和层压织物、纺织复合材料和纳米纤维的技术、加工、方法、建模和应用方面的文章。
免责声明:本网站所转载的文字、图片与视频资料版权归原创作者所有,如果涉及侵权,请第一时间联系本网删除。